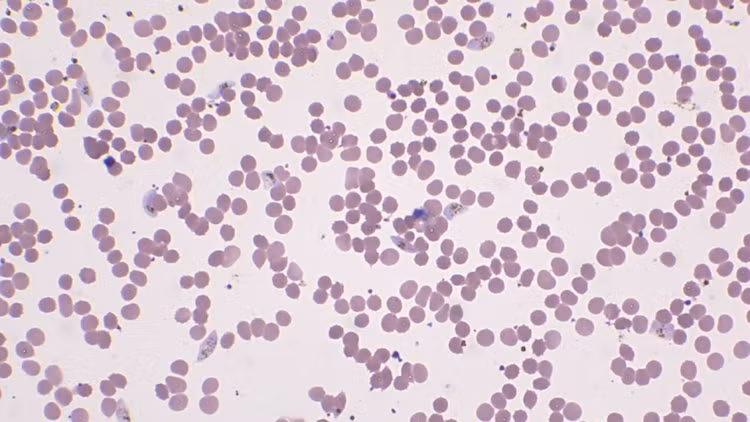
Khai quat mo co, phat hien bi mat gay am anh ca nhan loai-Hinh-11

![]() |
| Trong lịch sử, có những câu chuyện kỳ bí và đầy u ám về những cái chết bất thường của những gia tộc quyền lực. Một trong số đó là gia tộc Medici, những vị quý tộc nổi tiếng của Ý trong thời kỳ Phục hưng. Chính những cái chết đầy bí ẩn trong gia đình Medici đã gợi mở cho một loạt các giả thuyết và lời đồn đoán. |
![]() |
| Gia tộc Medici đã chiếm được vị thế thống trị ngành ngân hàng và trở thành một trong những gia tộc giàu có nhất thời đại. Nhưng đằng sau sự giàu có và quyền lực, gia đình này cũng rơi vào những cuộc đấu tranh và âm mưu quyền lực. |
![]() |
| Nhiều thành viên trong gia đình Medici đã trở thành nạn nhân của những vụ giết người, thậm chí đã được viết thành những cuốn tiểu thuyết nổi tiếng. |
![]() |
| Vương cung Thánh đường San Lorenzo ở Florence, nơi mà những người Medici được chôn cất như những vị vua chúa, trở thành điểm tập trung của những câu chuyện bí ẩn. Một số người tin rằng những ngôi mộ cổ xa hoa này chứa đựng những bí mật không thể lý giải về cái chết đồng loạt của những người Medici. |
![]() |
| Cuối cùng, một nhóm nghiên cứu do tiến sĩ Albert Zink, Giám đốc Viện nghiên cứu xác ướp của Ý, dẫn đầu đã có cơ hội khám phá những sự thật đằng sau cái chết bí ẩn của gia tộc này. |
![]() |
| Nhóm nghiên cứu đã tiến hành phân tích các mẫu mô nội tạng từ những bình trong hầm mộ giàu sang của Medici, tồn tại hơn 500 năm trước đây. Mục tiêu là tìm hiểu nguyên nhân gây cái chết đầy bí ẩn đeo bám gia tộc này. |
![]() |
| Những phân tích đầu tiên đã cho thấy một "kẻ giết ngấm" đáng sợ đang ẩn mình trong gia tộc Medici. Đó là Plasmodium falciparum, một loại ký sinh trùng gây sốt rét độc lực cao. |
![]() |
| Đây là lần đầu tiên mầm bệnh này được quan sát trực tiếp dưới kính hiển vi từ mẫu mô của một người chưa được xác định danh tính. Tuy nhiên, hầu hết các lọ nội tạng không ghi chú cụ thể cho từng cá nhân, điều này khiến việc xác định các nạn nhân cụ thể trở nên khó khăn. |
![]() |
| Theo nhóm nghiên cứu, nếu một người Medici mắc sốt rét, có khả năng cao rằng nhiều thành viên khác trong hầm mộ cũng đã bị lây nhiễm và chết vì cùng một lý do. Sốt rét là một căn bệnh nguy hiểm, và Plasmodium falciparum vẫn đang là một "kẻ giết ngấm" ám ảnh nhân loại cho đến ngày nay. |
![]() |
| Kết quả này không chỉ đánh giá lại quan điểm trước đây rằng Plasmodium falciparum chỉ tồn tại ở vùng nhiệt đới. Nó cũng đề cập đến khả năng căn bệnh này đã lan rộng hơn tưởng tượng ở Ý, một quốc gia có khí hậu ôn đới. Trước đây, người ta cho rằng sốt rét ở châu Âu do một loại ký sinh trùng yếu hơn gây ra. |
![]() |
| Các nhà nghiên cứu hy vọng rằng việc tiếp tục phân tích sâu hơn các mẫu mô sẽ cung cấp thêm thông tin để giải đáp những câu hỏi còn đang tồn đọng. Sự kết hợp giữa những lời đồn đoán huyền thoại và những phân tích khoa học này có thể giúp chúng ta hiểu rõ hơn về những cái chết bí ẩn trong gia tộc Medici và khám phá sự ám ảnh của Plasmodium falciparum. |
>>>Xem thêm video: Ớn lạnh thấy quan tài khắc “4 chữ tử” trong mộ cổ.